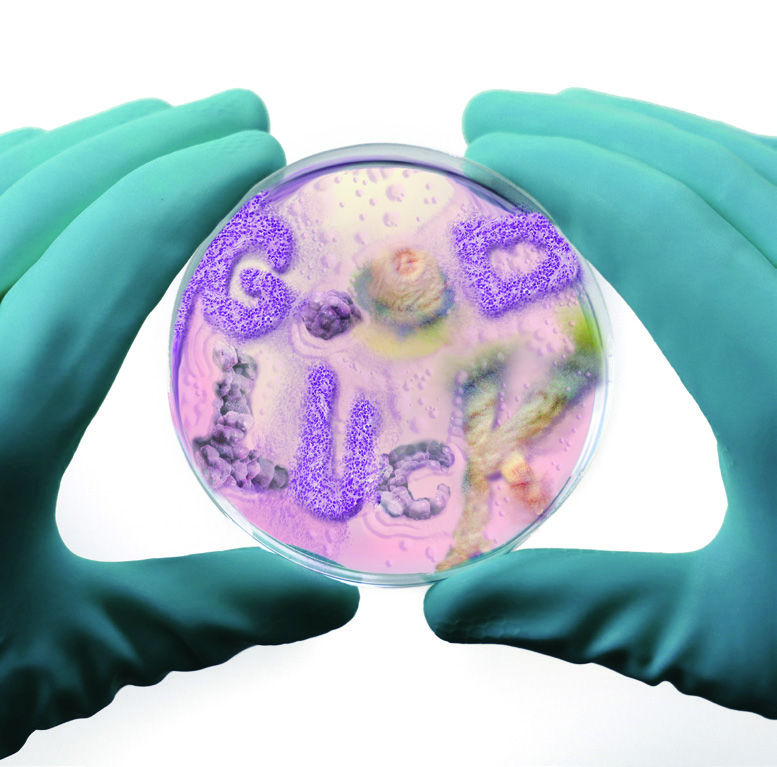
팬데믹에 대처하는 디자이너의 크리에이티비티 1 200525000000231 O
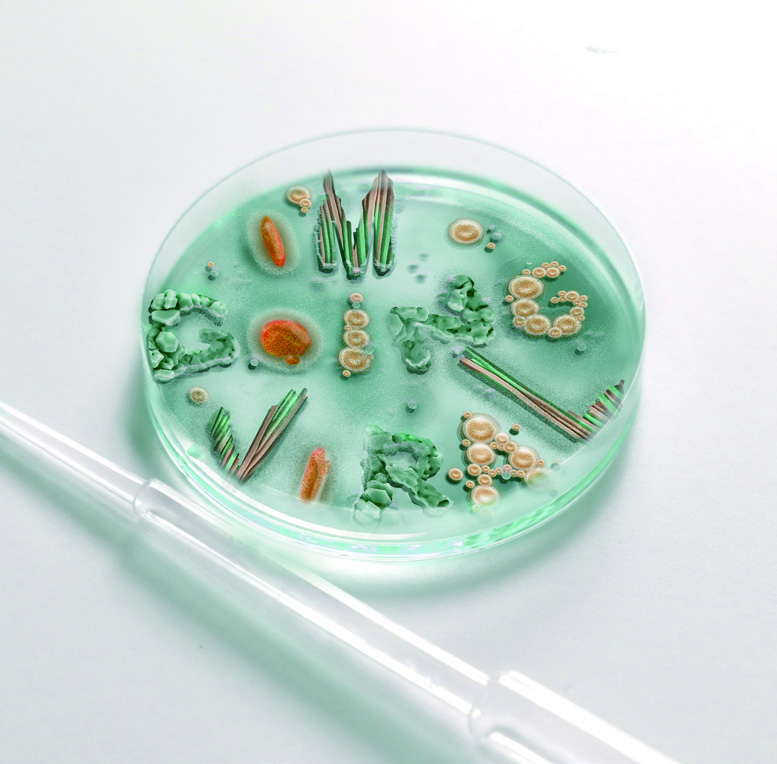
팬데믹에 대처하는 디자이너의 크리에이티비티 2 200525000000232 O
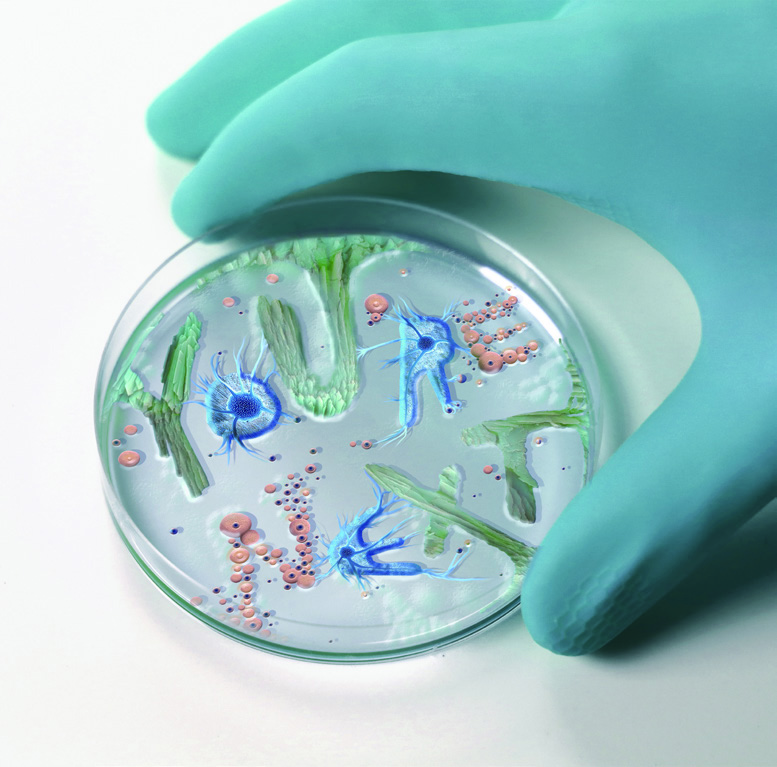
팬데믹에 대처하는 디자이너의 크리에이티비티 3 200525000000233 O

팬데믹에 대처하는 디자이너의 크리에이티비티
SNS는 코로나19 상황의 생활 문화사를 연구할 수 있는 거대한 디지털 유적지다. 많은 사람들이 새로 도래한 일상을 기록했고 크리에이터들은 서로를 응원하기 위해 각자의 방식으로 호쾌한 메시지를 업로드했다. 코로나19의 태풍 속에서 탄생한 이 이미지에서는 팬데믹 상황에서도 유머와 재치를 잃지 않은 선조들의 지혜를 엿볼 수 있다. the_last_dodo 런던을 기반으로 활동하는 그래픽 디자이너 사비에르 세거스Xavier Segers. 코로나 바이러스가 창궐한...

SNS는 코로나19 상황의 생활 문화사를 연구할 수 있는 거대한 디지털 유적지다. 많은 사람들이 새로 도래한 일상을 기록했고 크리에이터들은 서로를 응원하기 위해 각자의 방식으로 호쾌한 메시지를 업로드했다. 코로나19의 태풍 속에서 탄생한 이 이미지에서는 팬데믹 상황에서도 유머와 재치를 잃지 않은 선조들의 지혜를 엿볼 수 있다.

the_last_dodo 런던을 기반으로 활동하는 그래픽 디자이너 사비에르 세거스Xavier Segers. 코로나 바이러스가 창궐한 시대를 배경으로 한 가상 스토리와 함께 만든 타이포그래피다. 내용은 이렇다. 어느날 벨기에와 한국 과학자들이(사비에르 세거스는 벨기에-한국 혼혈이다) 어느 박테리아에 코로나 바이러스를 주입하는 실험을 벌였는데 그 결과로 이러한 이미지가 형성되었다는 내용. 아름다우면서 섬뜩하다.


dudewithsign 뉴욕 맨하탄의 사이다 세스Seth. 짧고 간결한 메시지를 적어보이는 퍼포먼스로 유명했다. 그는 코로나19 사태가 심각해지 자 거리에 나오는 대신 창 밖으로 피켓을 내보이는 식으로 대체했다. 물론 이래라 저래라 하지 말라는 악플도 늘 즐비했다.



jaimehayon 스페인 출신 디자이너 하이메 아욘Jaime Hayon. 코로나19로 침체에 빠졌던 한국, 이탈리아, 스페인을 위해 응원의 마음을 듬뿍 담은 메시지를 선보였다. 하트를 마구 마구 그려 넣은 드로잉에서 그의 긍정적인 기운이 물씬 풍긴다.



jay.lee.94801 키커랜드 디자이너 이재유Jay Lee. 코로나19로 칩거하던 시기에 만든 오브제다. 찌그러진 맥주캔으로 만든 오브제 ‘킹 코 로나’는 세상을 지배하고 있는 무자비한 코로나 바이러스를 왕으로 묘사한 것이다. 자세한 내용을 모두 읽어보는 것이 좋으니 페이스북 계정에 방문하기를 적극 추천한다.



roa_color 네덜란드 그래픽 디자이너 크리스토프 브래치Christop Brach와 다니에라 테 하허Daniera ter Hahar 의 합작이다. 재채기 한 번에 침방울이 10만개가 퍼져나온다는 사실을 아는가? 옷소매로 입과 코를 가리는 방법이 적극적으로 권고되는 이유다. 이들의 제시한 솔루션 은 양말의 발가락 부분을 자르고 발꿈치 부분을 팔꿈치에 맞춰 끼는 팔꿈치 양말이다.



pablo.rochat 각종 이모티콘과 디지털 디바이스를 이용해 유쾌한 비주얼을 선보이는 파블로 로챗 스튜디오Pablo Rochat Studio의 아트 디렉터. 모니터 속 이미지를 현실로 가장해 스테이 앳 홈Stay at home을 실천한 각종 방법(이라고 쓰고 몸부림이라고 읽는다)을 업로드했다.





